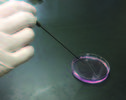
ステンレス培地吸引棒 バイオロジカルサクション

製品・サービス
セルバイオロジー/細胞実験
リアルタイム細胞解析
生きた細胞を培養しながら解析するリアルタイム細胞解析法(ライブセル解析法)は、薬剤などに対する細胞のカイネティックレスポンスを同じウェルから連続して解析することが可能です。
-
細胞を蛍光染色したりレポーター試薬を使うことなく非標識で経時的に解析したいと思ったことはありませんか?
xCELLigenceシリーズは、細胞増殖・細胞遊走・細胞浸潤・細胞形態変化などを同一ウェルから連続的に測定することができる装置です。がん免疫キリングアッセイ、細胞遊走・浸潤、ウイルスの細胞変性効果、iPS心筋細胞による心毒性試験、GPCRへのリガンドバインディング、タイトジャンクションアッセイなど様々セルベースアッセイにおすすめです。
3次元培養関連製品
3D培養あるいはオルガノイド培養の関連製品です。3D培養の創薬研究応用のための製品を中心に取り扱っています。
-
「3次元培養を創薬スクリーニングや個別化医療スクリーニングに活かしたい」
RASTRUM シリーズはそんな方のために作られました。
疾患表現型をできる限り反映する3D培養モデル(あるいはオルガノイド)を、これまでにない高い再現性で、ハイスループットに作製することを可能にします。
マトリクス(スキャフォールド)として、細胞外基質(ECM)を模倣した化学合成のハイドロゲル(RASTRUM マトリクス)を使用し、細胞を96ウェルプレートや384ウェルプレートに高速でプリンティングします。
基底膜マトリクス(マトリゲルなど)とマニュアルピペッティングによる3D培養プレート作製で直面する様々な課題を解決していただけます。
セルカウント(細胞計数)
培養細胞のカウントと生存率の測定は、継代培養、セルベースアッセイなど様々な場面で必須の実験手技です。弊社では、スライド要らずの画期的な自動セルカウンターを取り扱っています。
-
CellDropシリーズは、微量分光光度計の原理を応用して作られた初めての自動セルカウンターです。微量分光光度計と同様に、サンプルを直接装置に載せるだけの操作で、簡単かつ短時間で細胞のカウントが可能です。従来のセルカウンターのように使い捨てスライドを使用しません。
製品は4機種ございます。トリパンブルー法などによる明視野セルカウント専用のモデルと、蛍光セルカウントが可能なモデルがあり、それぞれ標準倍率(4x)と、高倍率(10x)モデルがございます。
細胞培養
動物細胞培養のためのCO2/マルチガスインキュベーターと培地アスピレーションのための吸引ツールをラインナップしています。
-
細胞培養における汚染対策を追求したユニークなCO2/マルチガスインキュベーターです。180℃乾熱滅菌+ファンレスデザイン+継ぎ目のない一体成型チャンバーにより、細菌等による庫内のコンタミを完全にリセットできます。
またマルチガスモデルは、O2濃度を0.2%までコントロールすることが可能で、癌細胞や幹細胞の低酸素培養に適しています。
-
従来のガラス製パスツールピペットでは、たびたび交換が必要でした。
バイオロジカルサクションであれば、使用時にガスバーナーで滅菌するだけで繰り返し使用することができます。